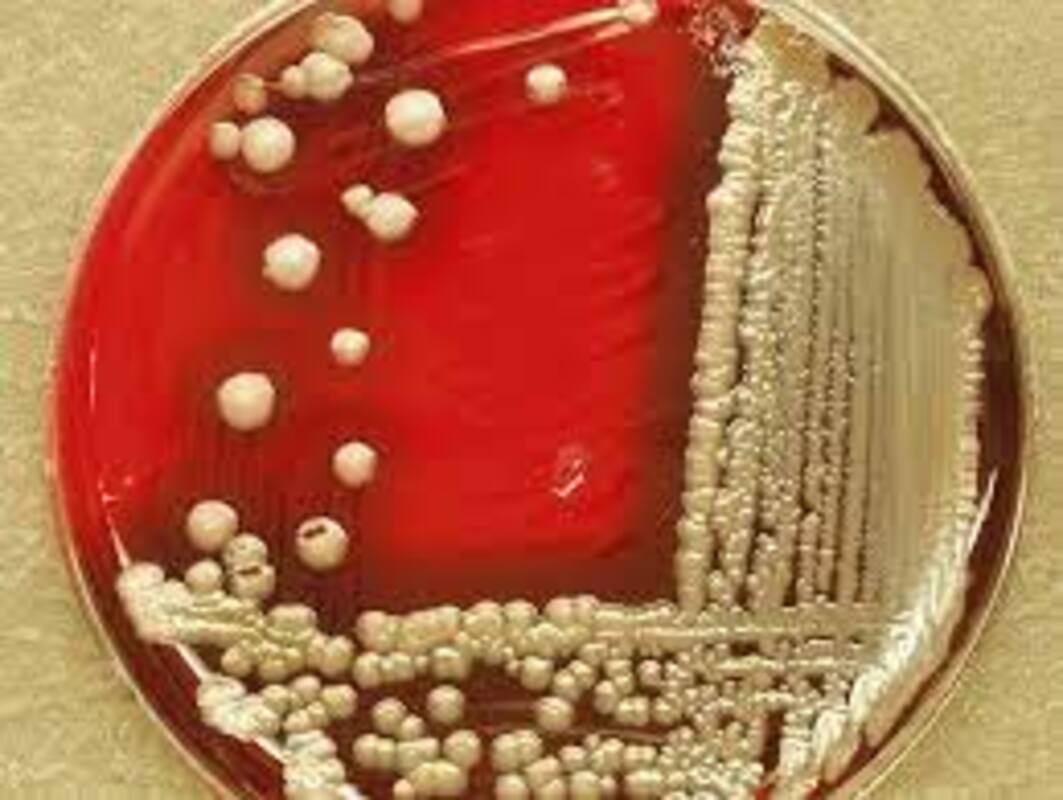
Bacillus cereus в упаковочных материалах: выявленное молекулярное и фенотипическое разнообразие (аннотация)

Представители группы Bacillus cereus были выделены из почвы, воды, растений и многочисленных пищевых продуктов.
Эти виды могут вырабатывать различные токсины, включая несколько энтеротоксинов [негемолитический энтеротоксин (Nhe), гемолизин BL (Hbl), цитотоксин K и энтеротоксин FM], эметический токсин цереулид и инсектицидные Bt-токсины. Это первое исследование, оценивающее присутствие B. cereus в упаковочном материале. Среди 75 различных изолятов были выявлены четыре филогенетические группы (II, III, IV и VI), из которых группы III и IV были наиболее многочисленными - 46,7 и 41,3% соответственно. Один изолят был отнесен к психротолерантной группе VI. Эксперименты по росту показали преобладание мезофильных микроорганизмов.
По результатам ПЦР-анализа гены nhe были обнаружены у 100% изолятов, а гены hbl - только у 50,7%. Ген, кодирующий цереулид, был обнаружен у четырех из 75 изолятов, ни один изолят не нес гена кристаллического токсина. Всего было выявлено тринадцать различных профилей генов токсинов. Мы показали, что разнообразные штаммы группы B. cereus могут быть обнаружены в упаковочном материале. Это разнообразие заключается в наличии четырех филогенетических групп, тринадцати профилей генов токсинов и различных температур роста.
Полученные результаты позволяют предположить, что упаковочный материал не содержит значительного количества высоковирулентных штаммов, а низкое количество штаммов, продуцирующих цереулид, согласуется с другими полученными данными.